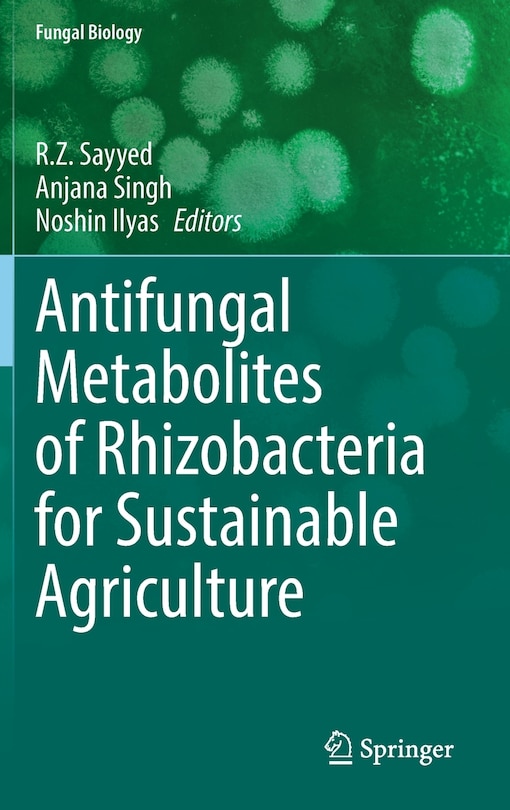
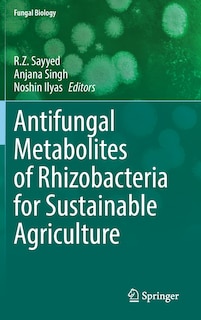

Free Preview of Antifungal Metabolites of Rhizobacteria for Sustainable Agriculture
$248.50
Online pricing. Prices and offers may vary in store.

Ship to me
Checking availability…
Buy now & pick up in store
Checking availability…
Find it in store
Checking availability…
Overview
Publisher: Springer Nature
Shipping dimensions: 9" H x 6" W x 1" L
ISBN: 9783031048043
Life stage: null
Ratings & Reviews
Others Also Bought
Antifungal Metabolites of Rhizobacteria for Sustainable Agriculture
/en-ca/antifungal-metabolites-of-rhizobacteria-for-sustainable-agriculture/A0EB3176-44D6-454D-8AD6-115D847BF26A.html
A0EB3176-44D6-454D-8AD6-115D847BF26A
Antifungal Metabolites of Rhizobacteria for Sustainable Agriculture
https://dynamic.indigoimages.ca/v1/books/books/3031048040/1.jpg
248.5
Antifungal Metabolites of Rhizobacteria for Sustainable Agriculture
https://dynamic.indigoimages.ca/v1/https://cdn.kobo.com/book-images/Images/642eb521-a17c-4383-ae22-f581e840f828/300/300/False/image.jpg
223.98